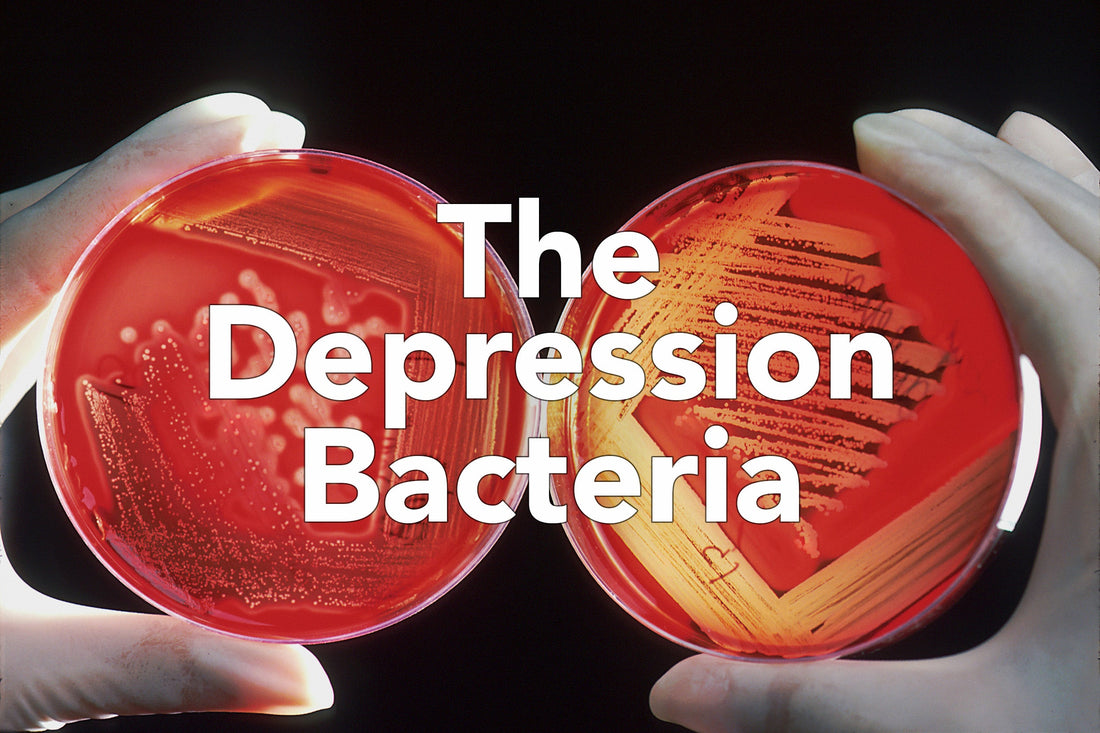

In recent years, the exploration of the gut-brain axis has gained significant traction in the realm of mental health research. Among the many fascinating findings, Harvard researchers have recently offered intriguing insights into how our gut bacteria, specifically a bacterium known as Morganella morganii, may play a pivotal role in fueling depression and inflammation.
The gut-brain axis refers to a complex communication network linking the gut and the brain. It encompasses biochemical signaling that takes place between the gastrointestinal tract and the central nervous system. The gut microbiome, a diverse community of microorganisms residing in our intestines, affects this interaction, influencing everything from digestion to mental health.
Among the numerous bacteria identified within the gut microbiome, M. morganii has emerged as a bacterium of interest. Initially recognized for its role in certain infections, researchers are now investigating its implications in mental health, particularly concerning inflammation and depression.
The study highlights that diethanolamine (DEA), an environmental contaminant used in various products, can replace sugar alcohol in a molecule produced by M. morganii in the gut. This altered molecule activates an immune response that the normal version does not, leading to the release of inflammatory proteins, particularly interleukin-6 (IL-6).
The authors suggest that this link creates a plausible connection between M. morganii and depression, as chronic inflammation is associated with various diseases, including depression. Previous research has also linked IL-6 to major depressive disorder and M. morganii to conditions like type 2 diabetes and inflammatory bowel disease (IBD).
Further research is needed to confirm whether this abnormal product from M. morganii directly causes major depressive disorder and to assess how many cases it might influence.
Depression is often associated with an imbalance in neurotransmitters like serotonin and dopamine. The research is uncovering that gut bacteria influence the production and regulation of these neurotransmitters. The presence of certain bacteria, including M. morganii, may alter the levels of these crucial mood-regulating chemicals, potentially causing depressive symptoms.
In addition, inflammation has been linked to various mood disorders. The inflammatory markers released by an imbalanced microbiome can enter the bloodstream and trigger an immune response in the brain, potentially leading to changes in behavior and mood regulation.
The insights from Harvard researchers emphasize the potential to develop new treatment methods aimed at restoring gut health as a strategy to combat depression. Probiotics, prebiotics, and dietary changes could aid in optimizing the gut microbiome and reduce inflammation. Focusing on a balanced diet rich in fiber, fermented foods, and low in processed sugars might mitigate some of the adverse effects associated with an overabundance of harmful gut bacteria like Morganella morganii... All things we've been saying for years!
As research continues to unravel the mysteries of the gut-brain connection, it becomes ever more evident that nurturing our gut health may yield significant benefits for our mental health and overall well-being. Embracing a diet that supports a healthy microbiome may be a promising step toward addressing mental health challenges like depression and inflammation.
Sources:
https://pubs.acs.org/doi/10.1021/jacs.4c15158?articleRef=test
https://www.sciencedirect.com/science/article/pii/S1876034123004550
https://pmc.ncbi.nlm.nih.gov/articles/PMC4367209
https://www.cdc.gov/niosh/npg/npgd0208.html
https://jneuroinflammation.biomedcentral.com/articles/10.1186/s12974-021-02100-7